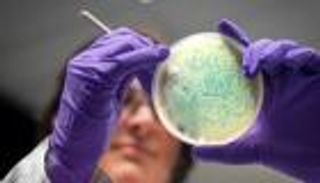
«السالمونيلا» لعلاج سرطان الأمعاء.. عندما يصبح الداء دواء

هل يساعد دواء السعال «ميوسينكس» في تحسين فرص الحمل؟

انتشرت مؤخرًا على منصة "تيك توك" فكرة مثيرة للجدل تربط بين دواء السعال "ميوسينكس"، الذي يحتوي على المادة الفعالة جوايفينيسين، وزيادة فرص الحمل.
استندت هذه الفكرة إلى تجارب فردية شاركتها بعض النساء، حيث أشرن إلى أن استخدامهن للدواء ساعد في تحقيق الحمل، ما أثار فضول الكثيرين حول صحة هذا الادعاء.
كيف قد يعمل "ميوسينكس" على تحسين فرص الحمل؟
يعتمد الدواء على مادة جوايفينيسين، وهي مخصصة لتخفيف الاحتقان وتقليل كثافة المخاط في الجهاز التنفسي.
يعتقد البعض أن هذه الخاصية قد تمتد إلى المخاط العنقي، الذي يلعب دورًا حيويًا في الخصوبة، إذ يساعد الحيوانات المنوية على الوصول إلى البويضة أثناء فترة التبويض.
في الحالات التي يكون فيها المخاط كثيفًا أو مفرط الكمية، قد يعيق ذلك حركة الحيوانات المنوية، ومن هنا جاءت الفكرة بأن جوايفينيسين يمكن أن يساعد في تحسين قوام المخاط العنقي وجعله أكثر ملاءمة لعملية الإخصاب.
الدليل العلمي والدراسات السابقة
رغم جاذبية هذه الفكرة، فإن الأدلة العلمية التي تدعمها محدودة للغاية.
واحدة من أبرز الدراسات التي تناقش تأثير جوايفينيسين على الخصوبة أجريت في عام 1982 على 40 زوجًا يعانون من مشكلات عنقية. ورغم الإشارة إلى وجود بعض التحسن في فرص الحمل، إلا أن الدراسة افتقرت إلى مجموعة ضابطة، مما يجعل من الصعب استخلاص نتائج دقيقة.
كما أشارت دراسة أخرى إلى زيادة مؤقتة في إنتاج الحيوانات المنوية وحركتها لدى رجل تناول جرعات عالية من جوايفينيسين، لكنها كانت حالة فردية وغير كافية لتأكيد فعالية الدواء كعلاج للخصوبة.
آراء الخبراء وتحذيرات الشركات المصنعة
أكدت شركة "ريكيت"، المصنعة لـ"ميوسينكس"، أن استخدام الدواء لتحسين الخصوبة لا يندرج ضمن الأغراض المصرح بها، مشيرة إلى ضرورة استخدامه فقط وفقًا للإرشادات المحددة على العبوة.
كما حذر الخبراء من الاعتماد على هذه الادعاءات، موضحين أن الأدلة العلمية الحالية غير كافية لتقديم توصيات باستخدام "ميوسينكس" لتحسين فرص الحمل.
بدائل صحية لتحسين الخصوبة
بدلاً من اللجوء إلى أدوية غير مخصصة لهذا الغرض، ينصح الأطباء النساء اللواتي يواجهن صعوبات في الحمل بالتركيز على نمط حياة صحي.
يمكن أن تساهم تغييرات بسيطة مثل الحفاظ على وزن مثالي، ومراقبة فترة التبويض، وتجنب عوامل الإجهاد في تعزيز فرص الحمل بشكل طبيعي.
ورغم أن فكرة استخدام "ميوسينكس" تبدو مغرية وسهلة التنفيذ، إلا أن الأفضل هو الحصول على استشارة طبية متخصصة لتحديد الخيارات الأنسب بناءً على الحالة الفردية، بدلاً من الاعتماد على تجارب غير مثبتة علميًا.